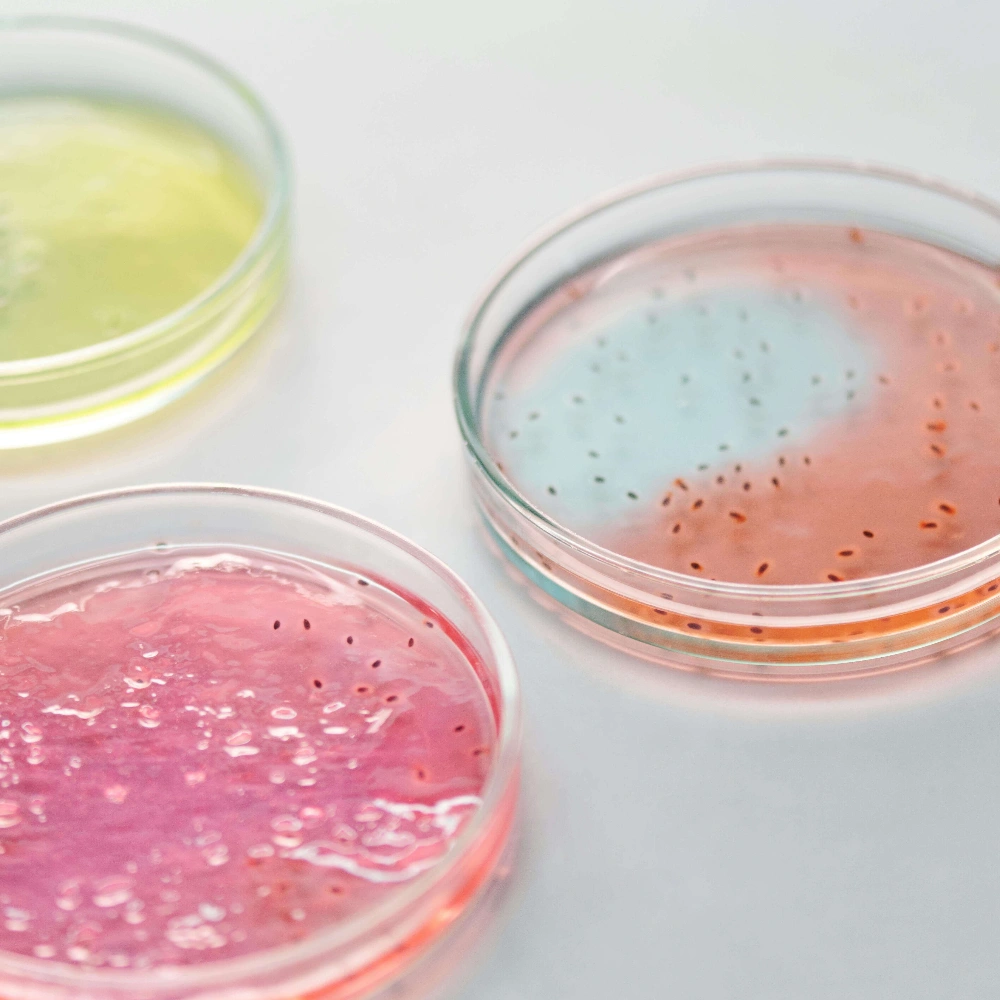
Afterschool elementary enrichment activities #8: Grow bacteria

Afterschool Enrichment Activities in 2026
reviewed by Jo-ann Caballes
Updated on January 12, 2026
Since the COVID-19 lockdown struck, students’ grades in math, English, and other key subjects have been slipping. On that note, teachers report that children have been less engaged in their learning since the pandemic.
Afterschool enrichment activities can help turn that around by regaining engagement and reinforcing key skills, ensuring children don’t fall behind in school. In this article, I will cover the best after-school enrichment activities for kids.
Key Points
- Afterschool enrichment activities can help combat learning loss over school holidays.
- Online math learning platforms are among the best afterschool enrichment activities out there.
- High schoolers prefer activities that improve their social and STEM skills, while elementary and middle school students prefer gamified learning activities.
Types of after-school enrichment activities
- Online after-school math programs
- Summer & winter camps
- Worksheets
- After-school book clubs
- Competitive quiz clubs
- Paying for small items
- Gardening
- Arts and crafts
- Grow bacteria and watch them develop
- Sports activities
- Playing board games
- Coding classes
- Building straw bridges
- Cooking together
- Debate classes
- Music activities
- Teaching language through TV and TikTok
Afterschool enrichment activities #1: Online after-school math programs
Age group: K-12
On top of my list of the best student activities are online afterschool math programs. As a professional tutor, I’ve seen firsthand how effective these programs can be, especially now, when so many children are still working to regain academic ground lost during the COVID-19 pandemic, and parents googling “afterschool enrichment activities near me.”
What are online afterschool math programs, and how can they be beneficial?
Online afterschool math programs are digital learning platforms designed to improve students’ math skills outside regular school hours. These are powerful tools to boost kids’ math education through interactive lessons, personalized learning paths, and engaging activities that make math feel approachable and fun.
Math tutoring classes as part of the academic activities have been a buzz for a long time, especially in the last five years. Online afterschool math programs revolutionized how children learn and interact with math, allowing flexible, hands-on learning.
Online math after-school enrichment programs are typically equipped with various interactive tools such as videos, games, quizzes, and practice problems. Some provide access to expert tutors, progress tracking, and instant feedback, which was previously only available through in-person tutoring.
If you feel like your child is falling behind in math, opting for an online after-school math program can be a good idea. For example, Brighterly math tutoring platform is a perfect option if you’re looking for one-on-one, gamified math tutoring for K-12 students.
Afterschool enrichment activities with Brighterly
Age group: K-12
Brighterly is an award-nominated online math tutoring platform, connecting the US K-12 students with expert math tutors. Brighterly focuses on play-based learning methods, unlike most math learning platforms, which use repetitive drills.
The Brighterly platform aims to be the #1 student-first tutoring service through:
- All-encompassing Common Core-aligned program
- Safe learning environment
- Hands-on, gamified math teaching
Brighterly math tutors are experts in engaging, motivating, and inspiring kids to learn mathematical concepts through effective research-based learning methods. The platform carefully selects each potential candidate to ensure every tutor is fully qualified and ready to make positive changes in the children’s educational journey.
Each Brighterly student gets a fully adapted math curriculum that is custom-designed to close their learning gaps and improve critical thinking and problem-solving. What’s more, the platform’s curriculum is constantly being updated by the best educators with research-based study resources, data, and STEM learning techniques.
Furthermore, Brighterly offers an affordable price beginning with $17.40/lesson, which is cost-effective compared to competitors on the market. For example, according to my research, the standard tutoring rate around the United States is between $20 and $80.
Check the basics behind this term
Take our quick quiz to discover the perfect learning solution based on your child’s needs.
Academic afterschool enrichment activities #2: Summer & winter camps
Age group: K-12

Children’s academic endeavors don’t have to end when the school holidays come. After school enrichment activities and summer programs can combat summer/winter learning loss. Studies have shown that if students participate in academic activities during the summer months, they are less likely to experience a loss in academic skills and knowledge before the start of the next school year.
Many platforms now offer structured academic components that focus on subjects like math, science, reading, and even coding – seasonal camps aren’t just about bonfires and crafts anymore (but just as fun!).
Furthermore, these camps can help children build soft skills such as communication, teamwork, and problem-solving. A change of environment is also beneficial, as children meet peers and build confidence in settings that are more relaxed than traditional school. What’s more, academic activities like summer and winter camps offer working parents a reliable way to keep their children in secure and productive environments.
Main summer & winter camps that you can enroll your kids in:
- Academic camps focusing on math, reading, writing, and test prep (e.g., Brighterly Summer/Winter camps)
- STEM camps focusing on science, technology, engineering, and math
- Arts & creative camps focusing on visual arts, drama, music, and creative writing
- Language & culture camps focusing on language learning
If you’re looking for summer school enrichment ideas for 2026 to improve your child’s math ability, Brighterly has something in store for you – a summer camp! It’s designed for children in grades 1 to 12 who are ready to upgrade their strengths, work through weaknesses, and prevent summer slide – where a prolonged break in learning, like summer vacation, can create gaps in a kid’s knowledge.
Click meBenefits of Brighterly summer camp:
- All-encompassing math curriculum based on Common Core
- Detailed progress reports for parents
- Homework help
- Modern, gamified, and adapted lessons
- Core skills focus
- More free time for parents
Check the basics behind this term
Take our quick quiz to discover the perfect learning solution based on your child’s needs.
Activities for elementary & middle school students: Worksheets
Another great enrichment activity for elementary and middle school students on my list is worksheets. Although overlooked, they can be extremely powerful and free afterschool enrichment activities for students.
If designed age-appropriately and interactively, with real-world problems featured, they help reinforce key concepts, build core skills, and encourage independent thinking. Additionally, worksheets can provide the necessary structure and support for long-term learning and productive practice.
If you’re looking for suggestions for afterschool program activities, I highly recommend Brighterly math worksheets. They illustrate math concepts in a way that’s visually engaging and interesting – there’s no learning by rote or repetitive sums.
Designed by the platform’s best educators, they provide step-by-step practice problems and real-world examples to simplify tough concepts. Brighterly worksheets are available by grade and also by types of math operations, including addition, subtraction, multiplication, division, measurements, and fractions.
Here’s an example of a 9th grade worksheet from Brighterly. 👇
And if you’re looking for after school enrichment activities for elementary students, here’s another example of a Brighterly worksheet for elementary students. 👇
Check the basics behind this term
Take our quick quiz to discover the perfect learning solution based on your child’s needs.
Afterschool enrichment activities #3: Afterschool book clubs
Age group: K-12

Afterschool book clubs are a great example of fun after-school student enrichment activities. And if they love reading, it won’t even feel like extra learning! This is a great enrichment activity for the kids that can be applied in all grades, from preschool up to grade 12. As kids progress through their grades, they’ll be given age-appropriate books to read.
Your kids can strengthen the following skills as part of a book club:
- Reading level
- Critical thinking skills
- Understanding hidden meanings
- Increasing vocabulary
- Improved writing skills
- Understanding problems
And did you know that book clubs can also be used as math after school enrichment activities for elementary students? Math involves a lot of reading, especially when it comes to engaging in math-based word problems. By being able to understand how questions are posed, kids can indirectly improve their math understanding! Educational after-school enrichment activities like these upgrade skills beyond traditional reading and writing.
Wonderful enrichment activity #4: Competitive quiz clubs
Age group: K-12
Kids love a bit of competition. Participating in after-school enrichment activities and classes like quiz clubs can streamline their learning for various subjects, including math, English, history and science. These enrichment activity examples will also bring out their competitive side in a healthy and appropriate way.
Schools can host weekly quizzes for kids – basically, a kid-friendly version of bar trivia many of us love to attend! They can offer prizes for each week’s winner and create a leaderboard throughout the school year to award a final winner. You can also host quizzes at home with the whole family as a fun afterschool student enrichment activity.
The best thing about quiz clubs is that they can be done in a range of formats, meaning kids and teens will never get bored. From question-and-answer rounds and music or video-based sections to interactive rounds, there’s plenty to keep kids engaged, entertained and educated.
Wonderful enrichment activity #5: Paying for small items
Age group: Kindergarten/elementary school
When you go to the shop with your kid, you can support them with basic math by allowing them to pay for a small treat themselves. For example, a bag of chips or a chocolate bar. In kindergarten, kids should be able to identify and use different coins and notes.
Letting them pay for their own little treats will help them add up small coins to the right amount, or learn to count their change if they pay with a note. As well as reinforcing basic math concepts, this math afterschool enrichment will make your kid feel super grown-up!
To further support money counting, you can use printable money worksheets by Brighterly – another one of the enrichment ideas for kids that can help boost math!
Afterschool enrichment activities for kids #6: Gardening
Age group: Any age

Gardening is an enrichment activity that kids can start in kindergarten and continue throughout their school years, getting more advanced as they grow. It’s also a wonderful enrichment activity to do together as a family or with friends. It’s also advantageous, as children can literally see the fruits of their labor.
It’s important to start small. Teach your kids how to pot bare plants and flowers and how to water them. Then, as they gain confidence, you can teach them more challenging gardening activities like weeding, composting, and mowing the lawn. Make it even more fun by incorporating creative activities – let your kids decorate their own pots first to give them a creative outlet and let them feel like their work is totally their own.
Your kids will enhance endless skills, including:
- Spatial awareness
- Hand-eye coordination
- Understanding how plants, flowers, and food grow
- Measuring soil, water, and plant food
- Regulate their emotional state and nervous system through gardening
It’s especially rewarding enrichment for kids as they can enjoy their fruits and vegetables once they’re fully grown!
Afterschool elementary enrichment activities #7: Arts and crafts
Age group: K-4

Who doesn’t love an arts and crafts activity? It’s one of the core elementary enrichment activities that can free their imagination and give them the space to be creative. As well as encouraging creativity, it can also enhance skills that are required in a lot of other subjects without them even realizing it. 👇
| Coloring | Helps kids understand color theory, as well as spatial awareness, learning to color within the lines. |
| Working together on a project | Builds teamwork and collaboration skills. |
| Coordination and fine motor skills | Some artsy tasks require precision, and this can help your kid improve their hand-eye coordination. |
| Understanding of measurements | Cutting and sticking together paper or other craft materials sometimes requires precise measurements – this is a great way to fine-tune a kid’s understanding of measurement. |
| Critical thinking skills |
If a child has been given a task, such as creating a specific item or shape using craft materials, it can enhance their critical thinking skills as they solve this problem; these skills are essential in math, science, and other core subjects. |
Arts and crafts can be delivered as enrichment classes for elementary students during or after school.
Afterschool elementary activities #8: Grow bacteria
Age group: K-7
You may read the title and go “What?!”, but hear me out.
Kids will learn about a range of scientific topics in elementary school, and chances are, bacterial growth will be on the list. You can reinforce this learning by growing bacteria as an afterschool enrichment activity.
All you’ll need are some Petri dishes with agar and some cotton swabs to pick up the material you want to test for bacteria. Swab it into the petri dishes, then watch over time as the bacteria grow and multiply.
This is a great way to visualize some of the key information your child will learn in school. Plus, as a bonus, it also works as one of the most interesting enrichment activities for kids.
Activities for elementary students #9: Sports activities
Age group: K-4

Playing sports is one of the fun, free afterschool enrichment activities for elementary students. Whether you play one-on-one games like catch with your kid, or they play bigger games with friends, they can enhance a lot of their school learning with sports.
Games like simple catch, or more challenging team games like football or basketball, are the best ways to improve their hand-eye coordination and fine motor skills. Frisbee games can also teach kids measurement if you’re able to measure how far their throws go. The fun nature of sports makes them great enrichment activities for the kids.
Other skills, like math, can be improved with team sports, too. Your kids can understand how to distribute teammates on a pitch using mathematical principles, or measure their performance, for example, the angle of their kicks or how fast they can run a certain distance. Sports are ideal elementary enrichment activities, and not only elementary.
Elementary afterschool enrichment activities #10: Playing board games
Age group: Any age

The best examples of enrichment activities for kids include board games. You probably already have them at home. If not, many public libraries offer board games for free!
Board games will not only enhance your kid’s learning but also allow you to spend some quality time together. Monopoly is a perfect math afterschool enrichment game – it teaches kids addition, subtraction, and budgeting. Plus, studies have shown that three-to-nine-year-olds who play board games, including Othello and Monopoly, have better math skills!
Word-based games, like Scrabble, Boggle, and Mad Libs, are an amazing way to reinforce English learning and increase your kid’s vocabulary.
Activities for middle school #11: Coding classes
Age group: Middle and high school
Coding is a pivotal skill for the future and a great example of enrichment classes for middle school. Not all public schools teach it as standard – only some states, including California, teach coding as a mandatory subject. Not only is it essential for the future workforce, but it’s also an excellent way to bolster learning in other subjects, including math.
Coding can easily be made fun – different after-school enrichment activities or programs that teach coding often do so via the medium of game coding. There’s nothing more rewarding than seeing a game brought to life by your own work!
Kids can also learn how to draw with code and understand specific key coding languages, including Python.
Fun afterschool enrichment activities #12: Building straw bridges
Age group: K-4
This enrichment activity can help with many hard and soft skills. Kids are usually put together in teams for communication, teamwork, and collaboration skills. They’re given straws and adhesive materials, including glue and tape, and are tasked with building the strongest bridge possible with the fewest resources.
Often, a cost will be attached to each item, for example, 10 cents per straw. This means that as your kid goes about building a strong bridge, they’ll also gain skills in addition to budgeting. For a more advanced way of delivering this wonderful enrichment activity, you can teach kids about the different types of bridges, including suspension, beam, and arch, so they can work out which option would be best for their bridge.
Afterschool enrichment activities middle school #13: Cooking together
Age group: K-8

The best examples of activities for kids in cooking include measuring out ingredients to reinforce math and learning to time each stage. Cooking or baking a recipe that has many steps and ingredients can also teach your kids how to multitask and use their time efficiently.
High school enrichment activity #14: Debate classes
Age group: High school
One of the greatest after school program ideas is debate classes. This is a perfect way to reinforce analysis and problem-solving skills.
Here are a couple of debate ideas:
- If the treatment of one country by another is fair and just
- Whether the government should provide aid to citizens, for example, free healthcare
- If drugs should be legalized
- How important climate change is, and whether governments need to do more
But debate class doesn’t have to be limited to social or political debates – any “debatable” topics will do.
Debate classes improve a range of skills, including public speaking, critical thinking skills, rationalization, listening, and communication. As your kid gets closer to college, these skills will be more important than ever.
Afterschool enrichment activities free #15: Music activities
Age group: K-12
There are a lot of ways music can be used as an afterschool enrichment activity. You could test your kids by getting them to identify the chords in their favorite songs or replicate their favorite hits on various instruments.
Playing an instrument naturally boosts hand-eye coordination and teaches rhythm and timing. Singing can be a great enrichment activity, too, as it can expand your teen’s vocabulary and raise confidence.
Afterschool enrichment activities #16: Learn languages through TV and TikTok
Age group: K-12
Different after school enrichment activities or programs for learning languages involve watching programs with subtitles. If your high schooler is learning a language, they’ll be at an advanced stage by this point. By giving them time to watch their favorite TV shows, but dubbed in their language of choice, they’ll learn as they enjoy.
This goes for other forms of video content, too, like TikTok. The platform encourages users to add subtitles to their videos, so by changing the language of the subtitles to their studied language, they can learn as they scroll.
Which after-school activity do elementary students like most?
As per my research, kids love sports activities the most, as they allow them to burn off excess energy, socialize with friends, and build confidence while having fun. Parents also report that it’s important to limit afterschool activities to twice a week.

Free afterschool enrichment activities for elementary students
- Arts and crafts
- Book clubs
- Puzzle games
- Nature-based activities
What are the best after-school activities for middle & high schoolers?
Some of the best afterschool activities for middle & high schoolers involve building social skills like debating classes, sports teams, theater groups, or wellness and personal growth.
Choose the best after school enrichment activities for your child
In 2026, it seems like you can’t go far without afterschool enrichment activities, as students’ grades in key subjects have been declining drastically. However, it doesn’t mean that every afterschool activity will do: parents and kids have to choose carefully, looking for programs that not only engage students but also support their academic, emotional, and social development.
If you’re looking for an afterschool math program that has:
- STEM-focused Common Core-aligned curriculum
- 24/7 support
- Research-based math teaching techniques
- And free printable study resources
Then Brighterly online math platform can be your ideal choice! Book a trial lesson today, and watch your child improve math skills and actually enjoy learning!



